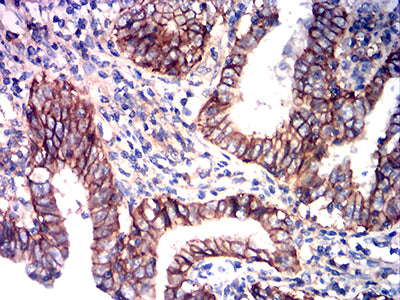

-
分类: 科研抗体货号: 31937别名: BSG; OK; 5F7; TCSF; EMMPRIN应用: IHC,FCM反应种属: Human
-
分类: 科研抗体货号: 31917别名: KLRK1; KLR; NKG2D; NKG2-D; D12S2489E应用: WB,FCM反应种属: Human, Rat
-
分类: 科研抗体货号: 31952别名: GS; GLNS; PIG43; PIG59应用: WB,IHC,FCM反应种属: Human, Mouse
-
分类: 科研抗体货号: 31935别名: PTPRC; LCA; LY5; B220; L-CA; T200; CD45; GP180应用: WB,IHC,IF,FCM反应种属: Human, Mouse, Rat
-
分类: 科研抗体货号: 31916别名: KLRK1; KLR; NKG2D; NKG2-D; D12S2489E应用: WB,FCM反应种属: Human, Rat
-
分类: 科研抗体货号: 31951别名: GS; GLNS; PIG43; PIG59应用: WB,IHC,IF,FCM反应种属: Human, Mouse
-
分类: 科研抗体货号: 31934别名: POMC; LPH; MSH; NPP; POC; CLIP应用: IF,FCM反应种属: Human
-
分类: 科研抗体货号: 31915别名: BWS; WBS; p57; BWCR; KIP2; p57Kip2应用: WB,IHC,IF,FCM反应种属: Human
-
分类: 科研抗体货号: 31950别名: HDR; HDRS应用: WB,IHC,FCM反应种属: Human
-
分类: 科研抗体货号: 31933别名: PR; NR3C3应用: WB,IHC,FCM反应种属: Human

鄂公网安备42018502007531号
鄂公网安备42018502007531号

